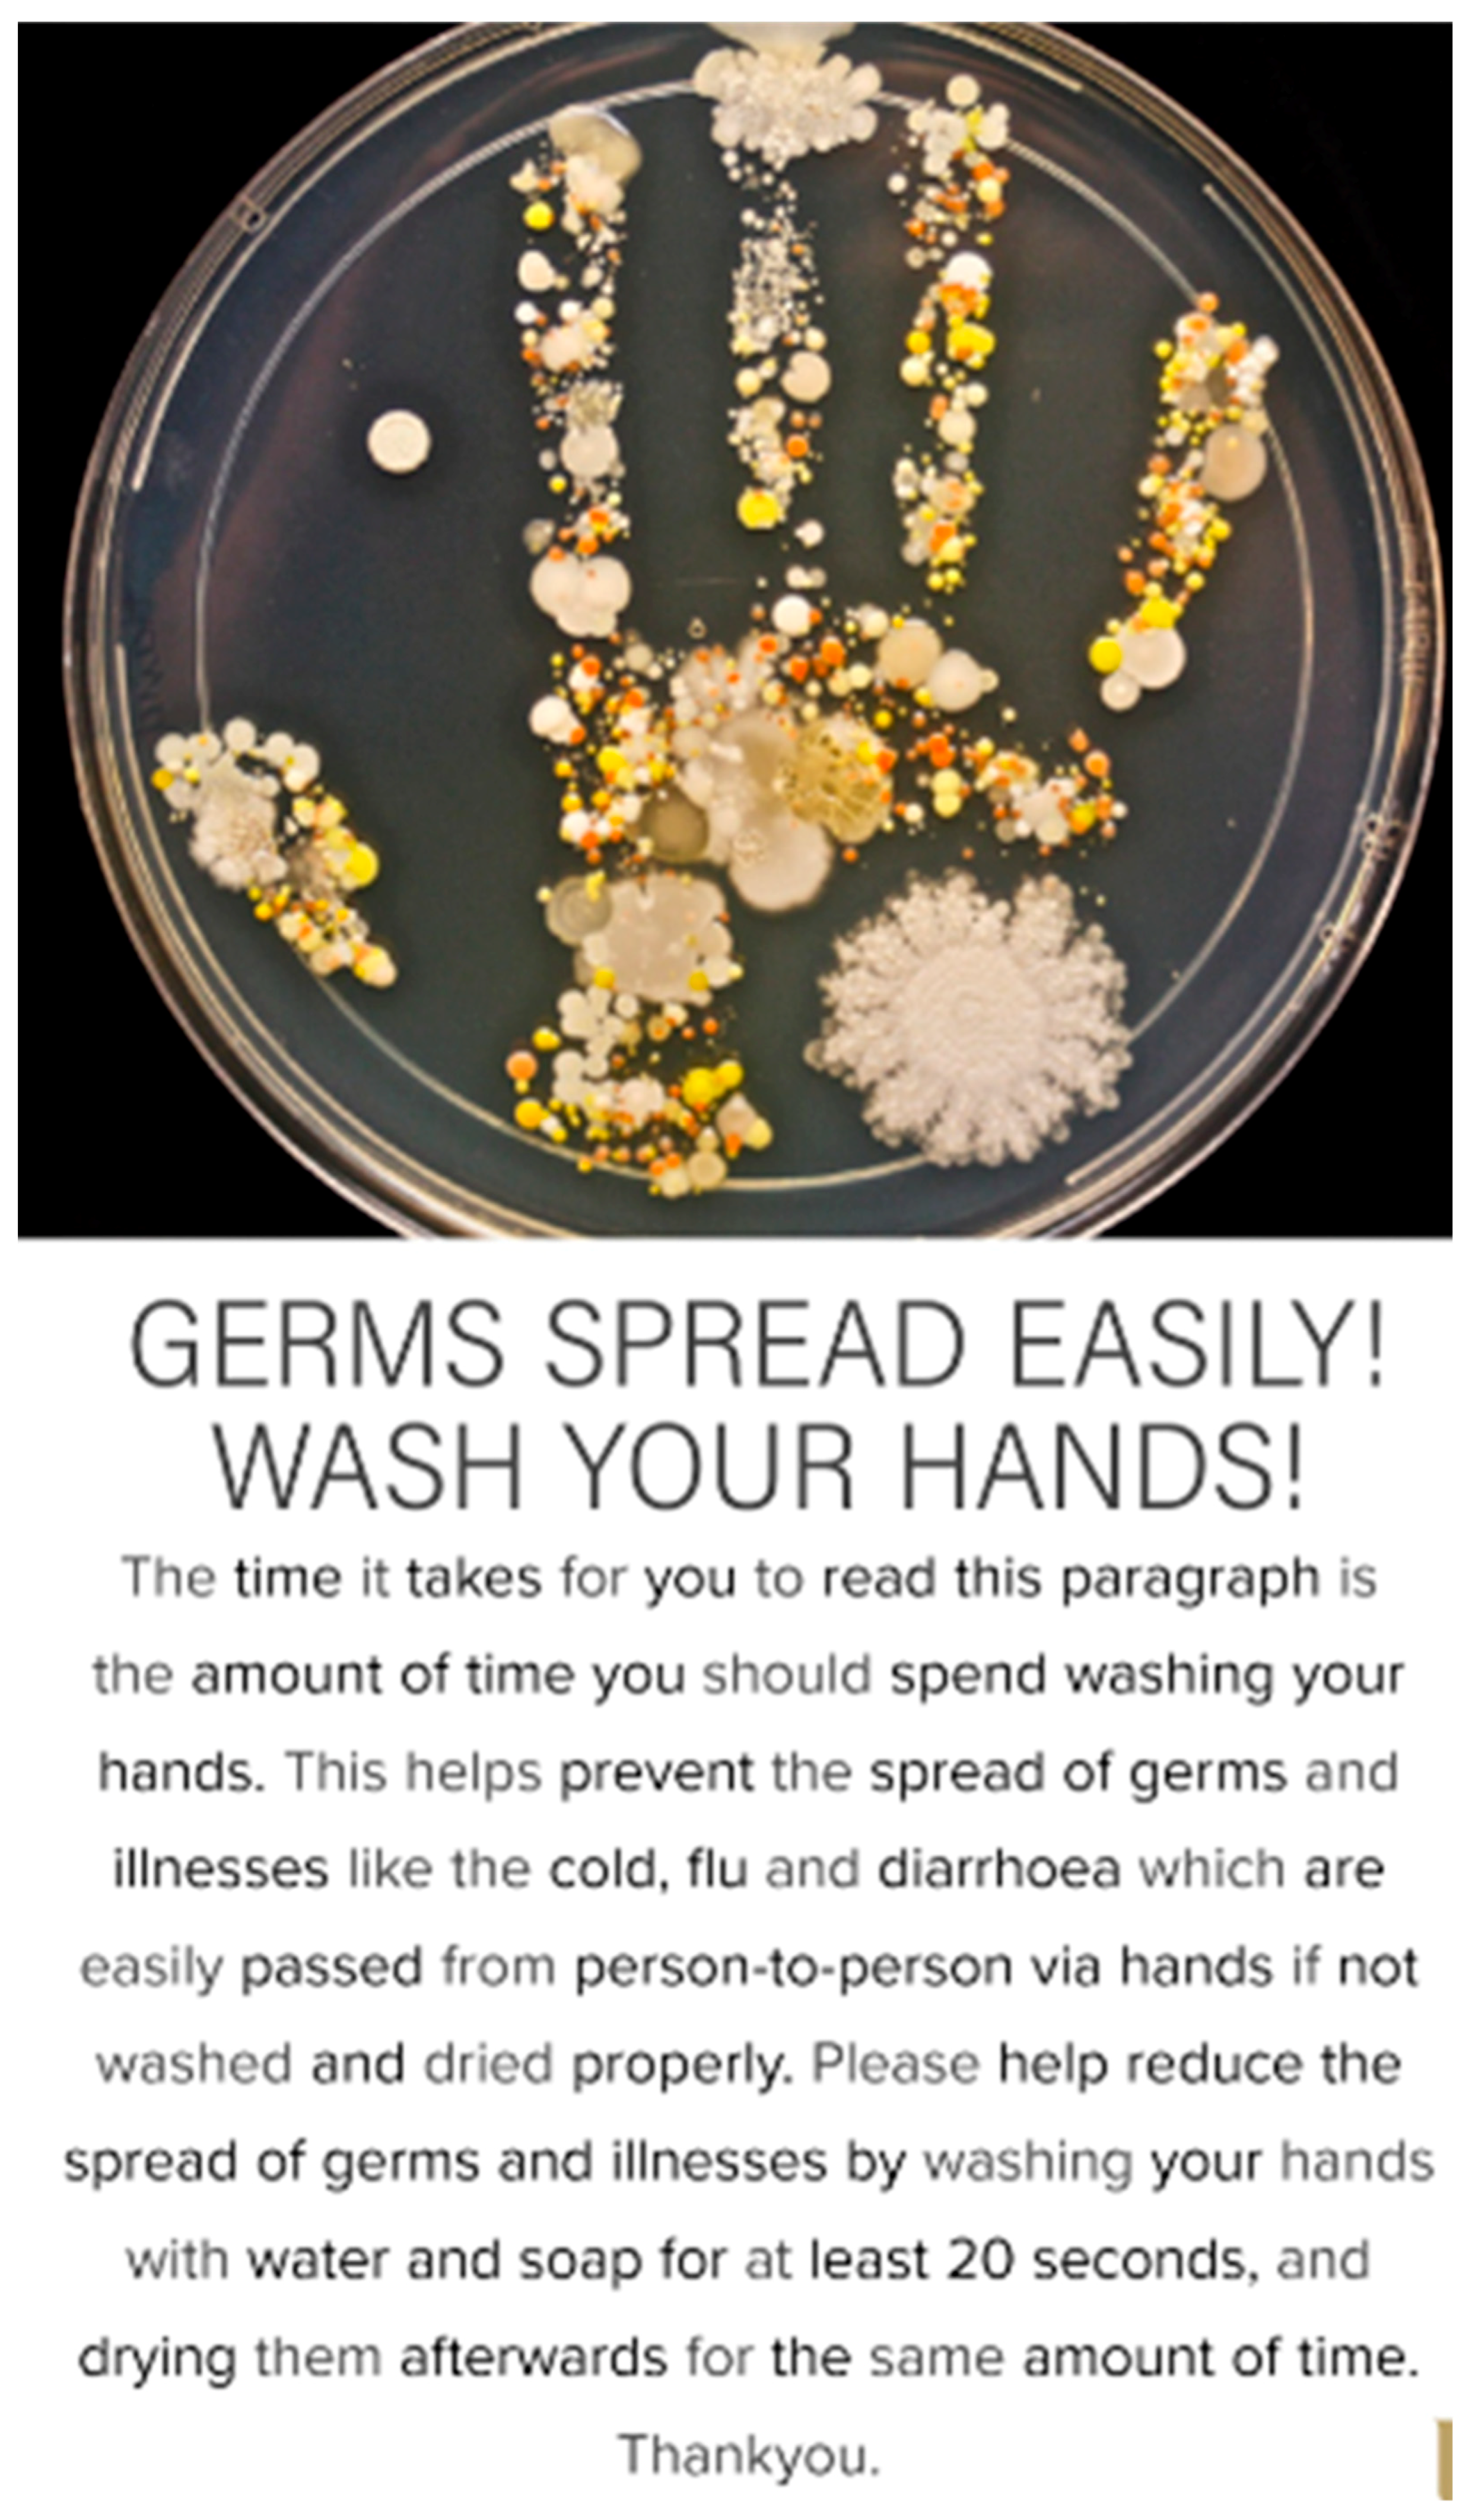

The Effectiveness of a Poster Intervention on Hand Hygiene Practice and Compliance When Using Public Restrooms in a University Setting
Abstract
1. Introduction
2. Materials and Methods
- Handwashing compliance (water alone)
- Handwashing compliance (with soap)
- Time spent washing hands (>20 s)
- Hand drying compliance
- Time spent drying hands (>20 s).
- Adequate hand hygiene compliance involves washing hands with water, soap and then lathering for twenty seconds or more and scrubbing in various rotations and interlocking of fingers, after which hands are rinsed with water to remove soap excess and then dried properly using an appropriate drying method (hand dryer or paper towels) for twenty seconds or more also.
- Basic hand hygiene involves washing hands with water, soap and scrubbing hands in various rotations and interlocking of fingers after which hands are rinsed with water to remove soap excess, and then dried afterwards using an appropriate drying method (hand dryer or paper towels).
- Poor hand hygiene involves either washing hands with water alone or not drying hands using an appropriate drying method (hand dryer or paper towels), or both.
- Non-hand hygiene involves not washing or drying hands.
Data Analysis
3. Results
4. Discussion
5. Conclusions
Author Contributions
Funding
Acknowledgments
Conflicts of Interest
References
- Bloomfield, S.F.; Aiello, A.E.; Cookson, B.; O’Boyle, C.; Larson, E.L. The effectiveness of hand hygiene procedures in reducing the risks of infections in home and community settings including handwashing and alcohol-based hand sanitizers. Am. J. Infect. Control 2007, 35 (Suppl. 10), S27–S64. [Google Scholar] [CrossRef]
- Hanson, J.; Bichard, J.; Greed, C. The Accessible Toilet Resource; U.C.L.: London, UK, 2007; Available online: http://eprints.ucl.ac.uk/4847/ (accessed on 10 November 2019).
- Curtis, V.; Cairncross, S. Effect of washing hands with soap on diarrhoea risk in the community: A systematic review. Lancet Infect. Dis. 2003, 3, 275–281. [Google Scholar] [CrossRef]
- Kagan, L.J.; Aiello, A.E.; Larson, E. The role of the home environment in the transmission of infectious diseases. J. Community Health 2002, 27, 247–267. [Google Scholar] [CrossRef] [PubMed]
- Allegranzi, B.; Gayet-Ageron, A.; Damani, N.; Bengaly, L.; McLaws, M.L.; Moro, M.L.; Memish, Z.; Urroz, O.; Richet, H.; Storr, J.; et al. Global implementation of WHO’s multimodal strategy for improvement of hand hygiene: A quasi-experimental study. Lancet Infect. Dis. 2013, 13, 843–851. [Google Scholar] [CrossRef]
- Barker, J.; Stevens, D.; Bloomfield, S.F. Spread and prevention of some common viral infections in community facilities and domestic homes. J. Appl. Microbiol. 2001, 91, 7–21. [Google Scholar] [CrossRef]
- Barker, J.; Jones, M.V. The potential spread of infection caused by aerosol contamination of surfaces after flushing a domestic toilet. J. Appl. Microbiol. 2005, 99, 339–347. [Google Scholar] [CrossRef]
- Clasen, T.F.; Bostoen, K.; Schmidt, W.P.; Boisson, S.; Fung, I.C.; Jenkins, M.W.; Scott, B.; Sugden, S.; Cairncross, S. Interventions to improve disposal of human excreta for preventing diarrhoea. Cochrane Database Syst. Rev. 2010, 16, CD007180. [Google Scholar] [CrossRef]
- Lowe, C.; Willey, B.; O’Shaughnessy, A.; Lee, W.; Lum, M.; Pike, K.; Larocque, C.; Dedier, H.; Dales, L.; Moore, C.; et al. Outbreak of Extended-Spectrum β-Lactamase–producing Klebsiella oxytoca Infections Associated with Contaminated Handwashing Sinks. Emerg. Infect. Dis. 2012, 18, 1242–1247. [Google Scholar] [CrossRef]
- Alharbi, S.A.; Salmen, S.H.; Chinnathambi, A.; Alharbi, N.S.; Zayed, M.E.; Al-Johny, B.O.; Wainwright, M. Assessment of the bacterial contamination of hand air dryer in washrooms. Saudi J. Biol. Sci. 2016, 23, 268–271. [Google Scholar] [CrossRef]
- Hateley, P.M.; Jurnaa, P.A. Hand washing. Hand washing is more common among healthcare workers than the public. BMJ 1999, 319, 519. [Google Scholar]
- Garbutt, C.; Simmons, G.; Patrick, D.; Miller, T. The public hand hygiene practices of New Zealanders: A national survey. N. Z. Med. J. 2007, 120, U2810. [Google Scholar] [PubMed]
- Curtis, V.A.; Danquah, L.O.; Aunger, R.V. Planned, motivated and habitual hygiene behaviour: An eleven-country review. Health Educ. Res. 2009, 24, 655–673. [Google Scholar] [CrossRef] [PubMed]
- Sultana, M.; Mahumud, R.A.; Sarker, A.R.; Hossain, S.M. Hand hygiene knowledge and practice among university students: Evidence from Private Universities of Bangladesh. Risk Manag. Healthc. Policy 2016, 9, 13–20. [Google Scholar] [CrossRef] [PubMed]
- Durell Johnson, H.; Sholcosky, D.; Gabello, K.; Ragni, R.; Ogonosky, N. Sex Differences in Public Restroom Handwashing Behavior Associated with Visual Behavior Prompts. Percept. Mot. Ski. 2003, 97, 805–810. [Google Scholar] [CrossRef]
- Surgeoner, B.V.; Chapman, B.J.; Powell, D.A. University students’ hand hygiene practice during a gastrointestinal outbreak in residences: What they say they do and what they actually do. J. Environ. Health 2009, 72, 24–28. [Google Scholar]
- Mariwah, S.; Hampshire, K.; Kasim, A. The impact of gender and physical environment on the handwashing behaviour of university students in Ghana. Trop. Med. Int. Health 2012, 17, 447–454. [Google Scholar] [CrossRef]
- Gould, D.J.; Moralejo, D.; Drey, N.S.; Chudleigh, J. Measuring hand washing performance in health service audits and research studies. J. Hosp. Infect. 2007, 66, 109e115. [Google Scholar] [CrossRef]
- Judah, G.; Aunger, R.; Schmidt, W.P.; Michie, S.; Granger, S.; Curtis, V. Experimental pretesting of hand-washing interventions in a natural setting. Am. J. Public Health 2009, 99 (Suppl. 2), S405–S411. [Google Scholar] [CrossRef]
- Contzen, N.; Meili, I.H.; Mosler, H.J. Changing handwashing behaviour in southern Ethiopia: A longitudinal study on infrastructural and commitment interventions. Soc. Sci. Med. 2015, 124, 103–114. [Google Scholar] [CrossRef]
- Pinfold, J.V. Analysis of different communication channels for promoting hygiene behaviour. Health Educ. Res. 1999, 14, 629–639. [Google Scholar] [CrossRef]
- Feather, A.; Stone, S.P.; Wessier, A.; Boursicot, K.A.; Pratt, C. Now please wash your hands’: The handwashing behaviour of final MBBS candidates. J. Hosp. Infect. 2000, 45, 62–64. [Google Scholar] [CrossRef] [PubMed]
- Hugonnet, S.; Pittet, D. Hand hygiene-Beliefs or science? Clin. Microbiol. Infect. 2000, 6, 350–356. [Google Scholar] [CrossRef] [PubMed]
- Anderson, M.E.C.; Sargeant, J.M.; Weese, J.S. Video observation of hand hygiene practices during routine companion animal appointments and the effect of a poster intervention on hand hygiene compliance. BMC Vet. Res. 2014, 10, 106. [Google Scholar] [CrossRef] [PubMed]
- Pfattheicher, S.; Strauch, C.; Diefenbacher, S.; Schnuerch, R. A field study on watching eyes and hand hygiene compliance in a public restroom. J. Appl. Soc. Psychol. 2018, 48, 188–194. [Google Scholar] [CrossRef]
- Harrison, B.L.; Ogara, C.; Gladstone, M.; Carrol, E.D.; Dusabe-Richards, J.; Medina-Lara, A.; Weeks, A. DWe have to clean ourselves to ensure that our children are healthy and beautiful: Findings from a qualitative assessment of a hand hygiene poster in rural Uganda. BMC Public Health 2019, 19, 1. [Google Scholar] [CrossRef]
- Biran, A.; Schmidt, W.-P.; Wright, R.; Jones, T.; Seshadri, M.; Isaac, P.; Curtis, V. The effect of a soap promotion and hygiene education campaign on handwashing behaviour in rural India: A cluster randomised trial. Trop. Med. Int. Health 2009, 14, 1303–1314. [Google Scholar] [CrossRef]
- Huda, T.M.; Unicomb, L.; Johnston, R.B.; Halder, A.K.; Yushuf Sharker, M.A.; Luby, S.P. Interim evaluation of a large scale sanitation, hygiene and water improvement programme on childhood diarrhea and respiratory disease in rural Bangladesh. Soc. Sci. Med. 2012, 75, 604–611. [Google Scholar] [CrossRef]
- Dreibelbis, R.; Kroeger, A.; Hossain, K.; Venkatesh, M.; Ram, P.K. Behavior Change without Behavior Change Communication: Nudging Handwashing among Primary School Students in Bangladesh. Int. J. Env. Res Public Health 2016, 13, 129. [Google Scholar] [CrossRef]
- Caris, M.G.; Labuschagne, H.A.; Dekker, M.; Kramer, M.H.H.; van Agtmael, M.A.; Vandenbroucke-Grauls, C.M.J.E. Nudging to improve hand hygiene. J. Hosp. Infect. 2018, 98, 352–358. [Google Scholar] [CrossRef]
- Jenner, E.A.; Jones, F.; Fletcher, B.C.; Miller, L.; Scott, G.M. Hand hygiene posters: Motivators or mixed messages? J. Hosp. Infect. 2005, 60, 218–225. [Google Scholar] [CrossRef]
- Anderson, J.L.; Warren, C.A.; Perez, E.; Louis, R.I.; Phillips, S.; Wheeler, J.; Cole, M.; Misra, R. Gender and ethnic differences in hand hygiene practices among college students. Am. J. Infect. Control. 2008, 36, 361–368. [Google Scholar] [CrossRef] [PubMed]
- Porzig-Drummond, R.; Stevenson, R.; Case, T.; Oaten, M. Can the emotion of disgust be harnessed to promote hand hygiene? Experimental and field-based tests. Soc. Sci. Med. 2009, 68, 1006–1012. [Google Scholar] [CrossRef] [PubMed]
- Willison-Parry, T.A.; Haidar, E.A.; Martini, L.G.; Coates, A.R. Handwashing adherence by visitors is poor: Is there a simple solution? Am. J. Infect Control 2013, 41, 928–929. [Google Scholar] [CrossRef] [PubMed]
- World Health Organisation (WHO). WHO Guidelines on Hand Hygiene in Health Care: A Summary: First Global Patient Safety Challenge Clean Care is Safer Care; WHO Press: Geneva, Switzerland, 2009; Available online: https://apps.who.int/iris/bitstream/handle/10665/70126/WHO_IER_PSP_2009.07_eng.pdf;jsessionid=6252CC72BB9805D8DC75F4DC86D124F2?sequence=1 (accessed on 4 October 2019).
- Oughton, M.T.; Loo, V.G.; Dendukuri, N.; Fenn, S.; Libman, M.D. Hand hygiene with soap and water is superior to alcohol rub and antiseptic wipes for removal of Clostridium difficile. Infect. Control Hosp. Epidemiol. 2009, 30, 939–944. [Google Scholar] [CrossRef] [PubMed]
- Patrick, D.R.; Findon, G.; Miller, T.E. Residual moisture determines the level of touch-contact-associated bacterial transfer following hand washing. Epidemiol. Infect. 1997, 119, 319–325. [Google Scholar] [CrossRef]
- Chou, D.T.; Achan, P.; Ramachandran, M. The World Health Organization ‘5 moments of hand hygiene’: The scientific foundation. J. Bone Jt. Surg. Br. 2012, 94, 441–445. [Google Scholar] [CrossRef]
- Center for Disease Control and Prevention (CDC). When and how to wash your hands. 2015. Available online: http://www.cdc.gov/handwashing/when-how-handwashing.html. (accessed on 11 November 2019).
- Mick, J.A. An alternative to singing “Happy Birthday”: Healthcare provider’s rhyme for handwashing time. Am. J. Infect. Control 2016, 44, 1759–1760. [Google Scholar] [CrossRef][Green Version]

| Hand Hygiene (HH) Compliance Category | Total Hand Hygiene Compliance Rate by Observation Period n (%) | |||||
|---|---|---|---|---|---|---|
| Pre-Intervention | Post-Intervention | |||||
| Total | Male | Female | Total | Male | Female | |
| Adequate HH | 54 (7.88) | 46 (8.29) | 8 (6.15) | 37 (7.97) | 26 (7.58) | 11 (9.09) |
| Basic HH | 350 (51.09) | 286 (51.53) | 64 (49.23) | 257 (55.39) | 181 (52.77) | 76 (62.81) |
| Poor HH | 119 (17.37) | 82 (14.77) | 37 (28.46) | 70 (15.09) | 40 (11.66) | 30 (24.79) |
| Non-HH | 162 (23.65) | 141 (25.41) | 21 (16.15) | 100 (21.55) | 96 (27.99) | 4 (3.31) |
| Total | 685 (100.00) | 555 (100.00) | 130 (100.00) | 464 (100.00) | 343 (100.00) | 121 (100.00) |
© 2019 by the authors. Licensee MDPI, Basel, Switzerland. This article is an open access article distributed under the terms and conditions of the Creative Commons Attribution (CC BY) license (http://creativecommons.org/licenses/by/4.0/).
Share and Cite
Lawson, A.; Vaganay-Miller, M. The Effectiveness of a Poster Intervention on Hand Hygiene Practice and Compliance When Using Public Restrooms in a University Setting. Int. J. Environ. Res. Public Health 2019, 16, 5036. https://doi.org/10.3390/ijerph16245036
Lawson A, Vaganay-Miller M. The Effectiveness of a Poster Intervention on Hand Hygiene Practice and Compliance When Using Public Restrooms in a University Setting. International Journal of Environmental Research and Public Health. 2019; 16(24):5036. https://doi.org/10.3390/ijerph16245036
Chicago/Turabian StyleLawson, Aaron, and Marie Vaganay-Miller. 2019. "The Effectiveness of a Poster Intervention on Hand Hygiene Practice and Compliance When Using Public Restrooms in a University Setting" International Journal of Environmental Research and Public Health 16, no. 24: 5036. https://doi.org/10.3390/ijerph16245036
APA StyleLawson, A., & Vaganay-Miller, M. (2019). The Effectiveness of a Poster Intervention on Hand Hygiene Practice and Compliance When Using Public Restrooms in a University Setting. International Journal of Environmental Research and Public Health, 16(24), 5036. https://doi.org/10.3390/ijerph16245036

